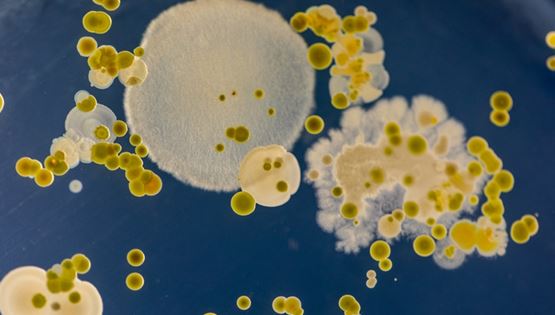
Ένας μύκητας 'σπέρνει' τον πανικό στα νοσοκομεία. Αλλά γιατί;

Ένας μύκητας 'σπέρνει' τον πανικό στα νοσοκομεία. Αλλά γιατί;
Δεν πρόκειται για νέα παγκόσμια επιδημία, το φαινόμενο όμως είναι ανησυχητικό.
Γραφει Νικη ΚοντομηναΠόση πρωτεΐνη χρειάζεσαι
Μήπως, στο πλαίσιο της αθλητικής διατροφής, το παρακάνεις με την πρωτεΐνη, με καταστρεπτικές συνέπειες για την υγεία σου;
Γραφει Γιαννης ΣπανοςΠώς να προπονείσαι μετά από αρθροπλαστική στο ισχίο ή τα γόνατα
Τα αθλήματα που επιτρέπονται και όλα όσα πρέπει να προσέχεις μετά από την επέμβαση.
O Jake Gyllenhaal και η προπόνηση που τον έκανε άλλο άνθρωπο για το Road House
O διάσημος ηθοποιός χρειάστηκε πολλή δουλειά για να μπει στο κινηματογραφικό σύμπαν του... UFC.
Γραφει Γιαννης ΣπανοςΑνοίγει ο δρόμος για μωρά με δύο βιολογικούς πατέρες
Δημιουργήθηκαν τα πρώτα ωάρια από αρσενικά κύτταρα ποντικιών.
Οι 3 κινήσεις του Terry Crews για σιδερένια μπράτσα
Μια γρήγορη προπόνηση για το άνω μέρος του σώματος, δοκιμασμένη από τον πρώην σούπερ σταρ του αμερικανικού φούτμπολ.
Γραφει Γιαννης Σπανος6 ασκήσεις μόνο χρειάζονται στο γυμναστήριο, και είναι του Arnold Schwarzenegger
Ο Arnold Schwarzenegger έχει περάσει όλη του τη ζωή στο γυμναστήριο και σίγουρα ξέρει καλύτερα από όλους μας.
Γραφει Γιαννης Σπανος